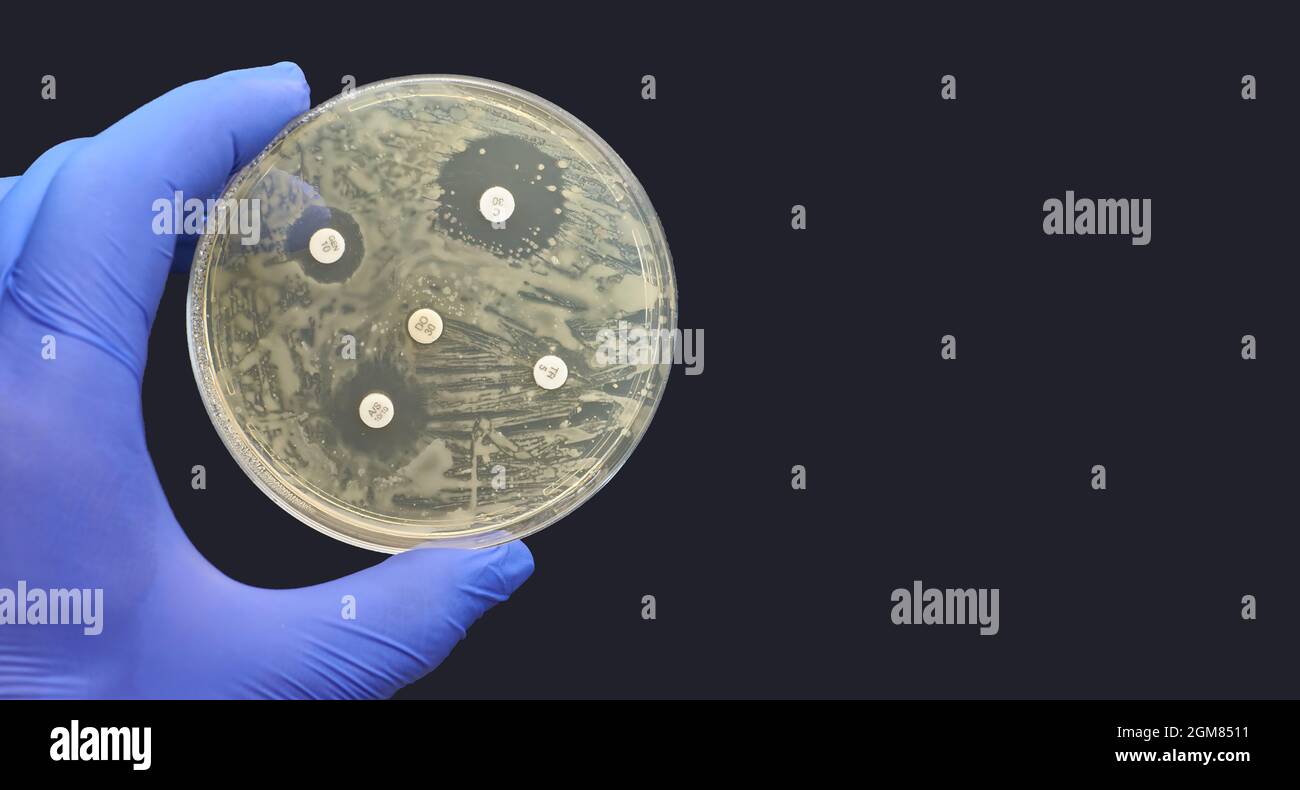
Kirby Bauer Disk Diffusion Antimicrobial Susceptibility Test Black Background Stock Photo Alamy

2

Kirby Bauer Disc Test Kirby Bauer Antimicrobial Susceptibi Flickr

Kirby Bauer Disc Diffusion Method For Antibiotic Susceptibility Testing Youtube

Stokes Disc Diffusion Method Principle Procedure Results Microbe Online

Kirby Bauer Disk Diffusion Susceptibility Test Protocol Asm Org

Labtholog Y On Twitter The Kirby Bauer Disk Diffusion Test Is A Standardized Protocol For Determining Antibiotic Susceptibility A Pure Culture Of The Test Organism Is Inoculated On Mueller Hinton Agar Https T Co 1xbstkcdtj

Solved Kirby Bauer Test Compare And Interpret The Results Chegg Com
Antibiotic Sensitivity Test By Kirby Bauer Method Medical Laboratories
Kirby Bauer Disk Diffusion Antimicrobial Susceptibility Test Black Background Stock Photo Alamy

Solved Kirby Bauer Antimicrobial Susceptibility Test Chegg Com

Can Disc Diffusion Susceptibility Tests Assess The Antimicrobial Activity Of Engineered Nanoparticles Springerlink